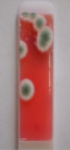

Мы приняли вашу заявку, свяжемся с вами в ближайшее время.

История
Часть товаров из корзины будет перемещена в статус отложенных и не сможет быть оформлена для заказа, если вы продолжите работу в данном регионе
История

История
История
Контактные экспресс-тесты предназначены для проведения санитарного контроля на производствах, торговых предприятиях и организациях общественного питания методами отпечатка и взятия смывов с рабочих поверхностей, оборудования, рук персонала и воды, а также для оценки качества дезинфекции. Экспресс-тест представляет собой пробирку с завинчивающейся крышкой и пластину с обеих сторон покрытую плотной питательной средой. Для применения необходимо окунуть пластинку в пробу на 5-10 секунд или прикоснуться платиной на короткое время к тестируемой поверхности и затем закрутить её обратно в пробирку и поставить в тёмное прохладное место.
Экспресс-тесты Биоконтроль обеспечивают:
|

|
 |
 |
 |
 |
|
 |
С помощью личного кабинета Вы сможете:
Сравнение